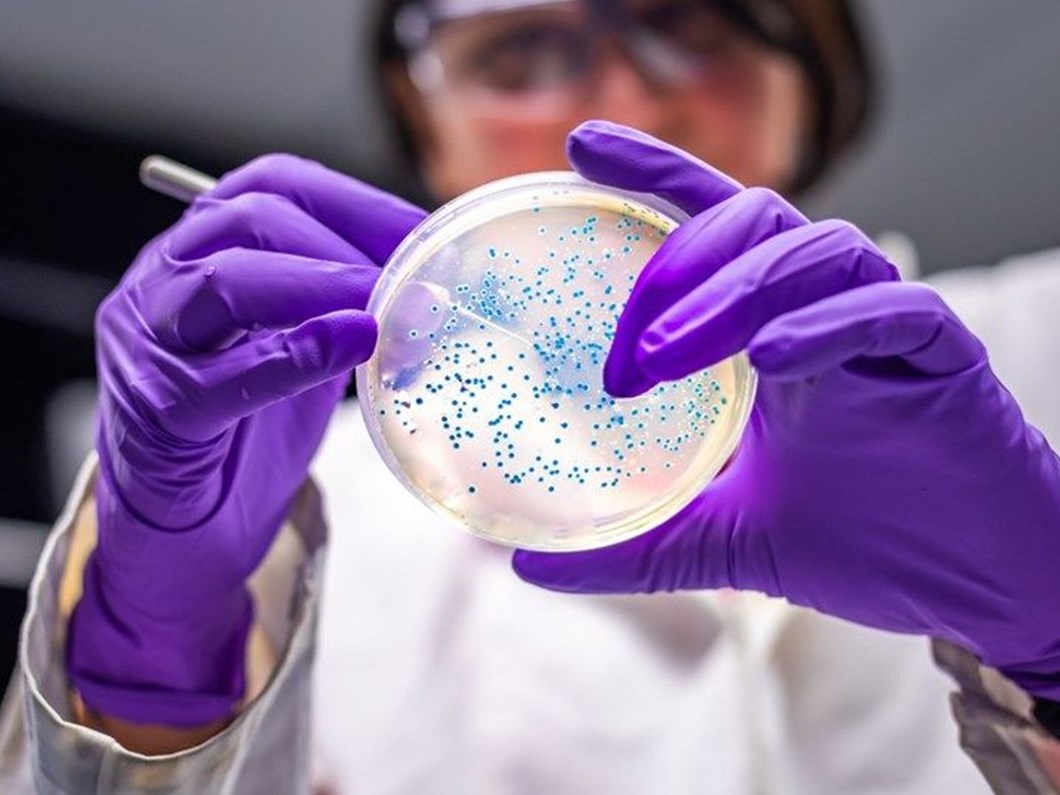

İlk olarak Hindistan'da doğrulanan Kovid-19 Delta mutasyonu dünyayı alarma geçirirken, Japon bilim adamları söz konusu mutasyonun bulaşma riskine dair bir bilimsel araştırma gerçekleştirdi. Kyoto Üniversitesi Profesörü Hiroshi Hishiura ve Hokkaido Üniversitesi Profesörü Kimihito Ito liderliğindeki bir grup, Tokyo'da yapılan PCR testlerinin sonuçlarını ve uluslararası bir korona virüs veritabanını inceledi. Bir taşıyıcının virüsü bulaştıracağı ortalama insan sayısı açısından, Delta mutasyonunun virüsten 1.95 kat daha bulaşıcı olduğunu tespit eden ekip, çalışma sonuçlarını Japonya Sağlık Bakanlığı'na sundu.
OLİMPİYAT UYARISI
Japonya'dan gelen verilere dayanarak, mutasyonun 12 Temmuz'a kadar yeni vakaların yarısından fazlasını oluşturabileceği uyarısı yapan uzmanlar, Tokyo Olimpiyatları'nın başlangıç tarihi olan 23 Temmuz'da, Delta mutasyonunun ülke çapındaki günlük yeni vakaların yüzde 68.9'unu oluşturmasının beklendiğini açıkladı.
Japonya'da Kovid-19 vakalarının toplam sayısı dün itibariyle 791 bin 699'a ulaşmış, ölü sayısı da 14 bin 618'e yükselmişti.